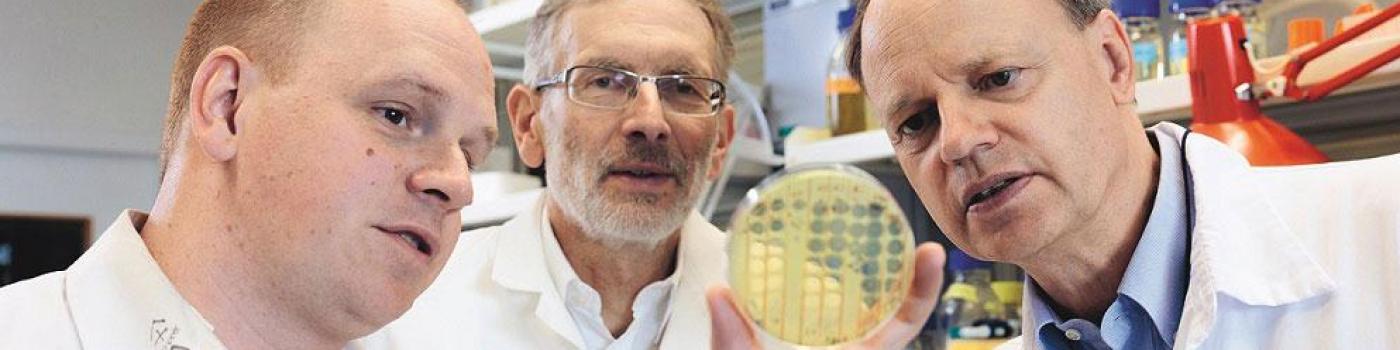
Antibiorésistance

Une équipe multidisciplinaire des HUG et de l’Université de Genève est parvenue pour la première fois, à l’aide de bactériophages, à traiter avec succès un patient souffrant d’une infection bactérienne pulmonaire chronique résistante aux antibiotiques.
Cette première suisse a été réalisée grâce à une approche multidisciplinaire et hautement personnalisée consistant à sélectionner un bactériophage (virus qui s’attaque aux bactéries) spécifique aux bactéries multirésistantes du patient. Les phages font partie des stratégies envisagées pour combattre le fléau de l’antibiorésistance bactérienne. Toutefois, il reste beaucoup à faire afin de sélectionner ceux qui sont spécifiques à chaque personne, établir les protocoles de traitement, connaître les effets secondaires et éviter l’émergence de souches résistantes aux phages. Ces résultats font l’objet d’une publication dans la revue Nature Communications : Personalized aerosolised bacteriophage treatment of a chronic lung infection due to multidrug-resistant Pseudomonas aeruginosa
Texte:
- Giuseppe Costa
Photos:
- HUG